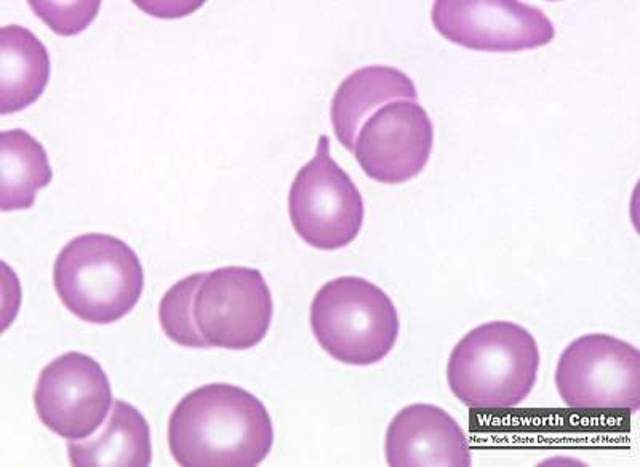
Cell and Microscope

-
Robert Hooke introduced the term "cells" and Anton Van Leeuwenhoek observed the first microorganisms because of the invention of the microscope.
-
-
Gregor Mendel, an Austrian monk working with pea plants, discovered the simple laws of inheritance of traits that allowed one to predict the outcome of crosses with certain traits.
-
Lois Pasteur described the scientific basis for fermentation, wine making, and the brewing of beer, established the science of microbiology, and proposed the Germ Theory, claiming that microorganisms were responsible for infectious diseases.
-
Johann Miescher found nucleic acid in white blood cells from pus in bandages. This led scientist to believe that DNA might be inherited
-
-
Thomas Hunt Morgan discovered that genes were on chromosomes.
-
Fred Griffith proved that genetic material could be moved from one strain of bacteria to another
-
Sir Alexander Fleming isolated penicillin from a fungus. We still use his techniques today
-
Chargaff showed that in DNA the number adenine equaled those of thymine and the number of units of cytosine equaled those of guanine
-
Beadle and Tatum proposed the “one gene produces one enzyme” hypothesis.
-
Avery, McCarthy, McLeod established that indeed DNA was the hereditary material that was transferred.
-
Using their famous “blender experiment” Hershey and Chase proved viruses replicated using DNA and confirmed the role of DNA as the hereditary material.
-
Rosalind Franklin and Maurice Wilkins established through X-ray crystallography that DNA was indeed a double helix.
-
Watson and Crick discovered the structure of DNA.
-
Hayes discovered plasmid DNA, circular pieces of DNA found in bacteria.
-
Walter Gilbert discovered the mechanism of gene expression through his study of messenger RNA.
-
Arber, Nathans, and Smith discovered bacterial restriction enzymes that cut DNA.
-
Khorana and Nirenberg discovered the 64 codons that code for the 20 amino acids making up proteins.
-
DNA plasmids were isolated and purified by Vinograd.
-
-
Madel and Higa were responsible for the 1st transformation of bacterium Escherichia coli.
-
Cloning experiments were conducted by Boyer and Cohen.
-
Genentech, the world’s first genetic engineering company, was founded.
-
140 scientists met to draw up guidelines for work with recumbent DNA in microorganisms. Paul Berg was key organizer.
-
Sanger and Gilbert found a way to sequence DNA.
-
Boyer inserted a synthetic insulin gene into E. coli.
-
Botstein found that a person could be identified by the pattern made of one’s DNA. The DNA fingerprint was called a Restriction Fragment Length Polymorphism.
-
Louise Joy Brown was born, the 1st human in vitro fertilization, in which sperm and egg are joined in a petri dish. The fertilized egg is later implanted in a womb.
-
The U.S. Supreme Court ruled that genetically altered life forms can be patented. Resulting in a huge startup of biotech companies.
-
Ohio university scientists made the first transgenic animals.
-
Eli Lilly Company placed a human insulin gene inside bacteria.
-
Schell, Chilton, Van Montagu, Fraley, and Horsch Transformed plants with Agrobacterium-mediated gene transfer.
-
Kary Mullis invented polymerase chain reaction to amplify DNA in the laboratory.
-
Jeffries applied RFLP in DNA profiling to the study of criminal cases.
-
An automated Flourescence sequencer was invented, speeding up the labor-intense process.
-
Genes were moved into an organism through the use of a gene gun.
-
NIH revised safety guidelines for Recombinant DNA to include plants grown in greenhouses and animals raised in barns.
-
Andrew Fire and Craig Mello discovered RNA interference, silencing of genes, in worm C. elegans.
-
Kohler, Milstein, and Jerne used monoclonal antibody technology.
-
Maynard Olson and colleagues at Washington University Invented “yeast artificial chromosomes,” or YACs, which are expression vector s for large proteins.
-
Ian Wilmut Cloned Dolly the sheep from an adult cell of a ewe at the Roslin Institute in Scotland.
-
DNA microarray technology, looking at the expression of all the genes of an organism at one time on a microscope slide or silicon chip, was developed
-
Dabiri and Garner invented an automated DNA sequencer that had the capability of sequencing 76,800 base pairs per hour. This greatly sped up Human Genome Project.
-
Ron Breaker coined the term riboswitch for part of an mRNA molecule that can regulate its own activity and therefore gene expression.
-
Announcement was made of the completion of the Human Genome Project by Francis Collins and Craig Venter. The project provided the ability to find genes and gave rise to the sequencing of other genomes.
Plan projects on a visual timeline
Map milestones, phases, deadlines, and key events in one place so the sequence is easier to see and share. Timetoast is a timeline maker for work, school, research, and stories.